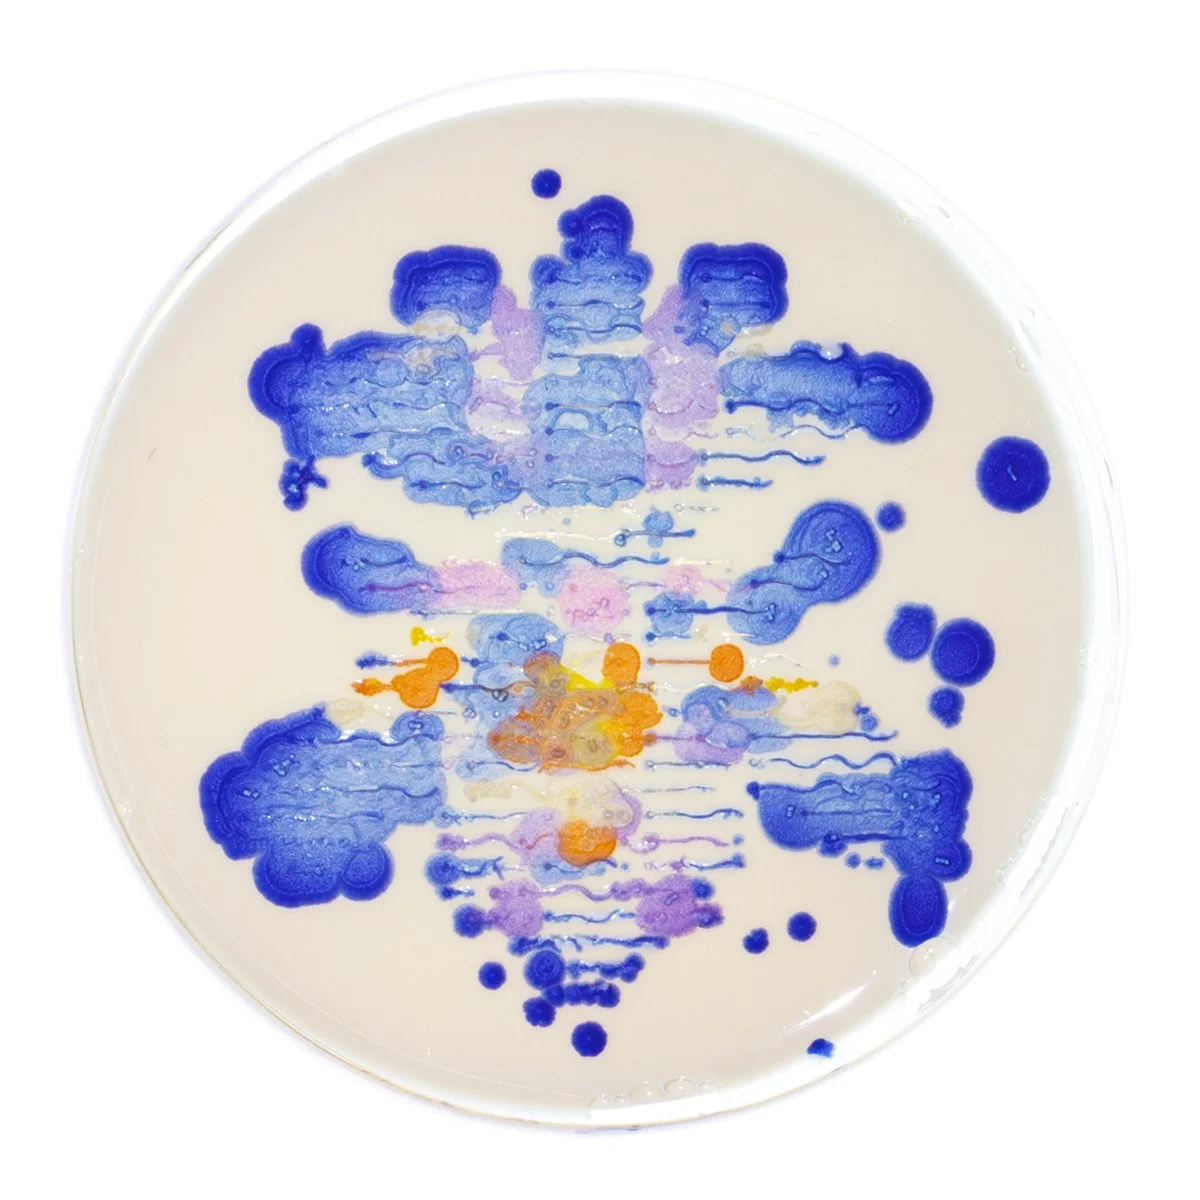
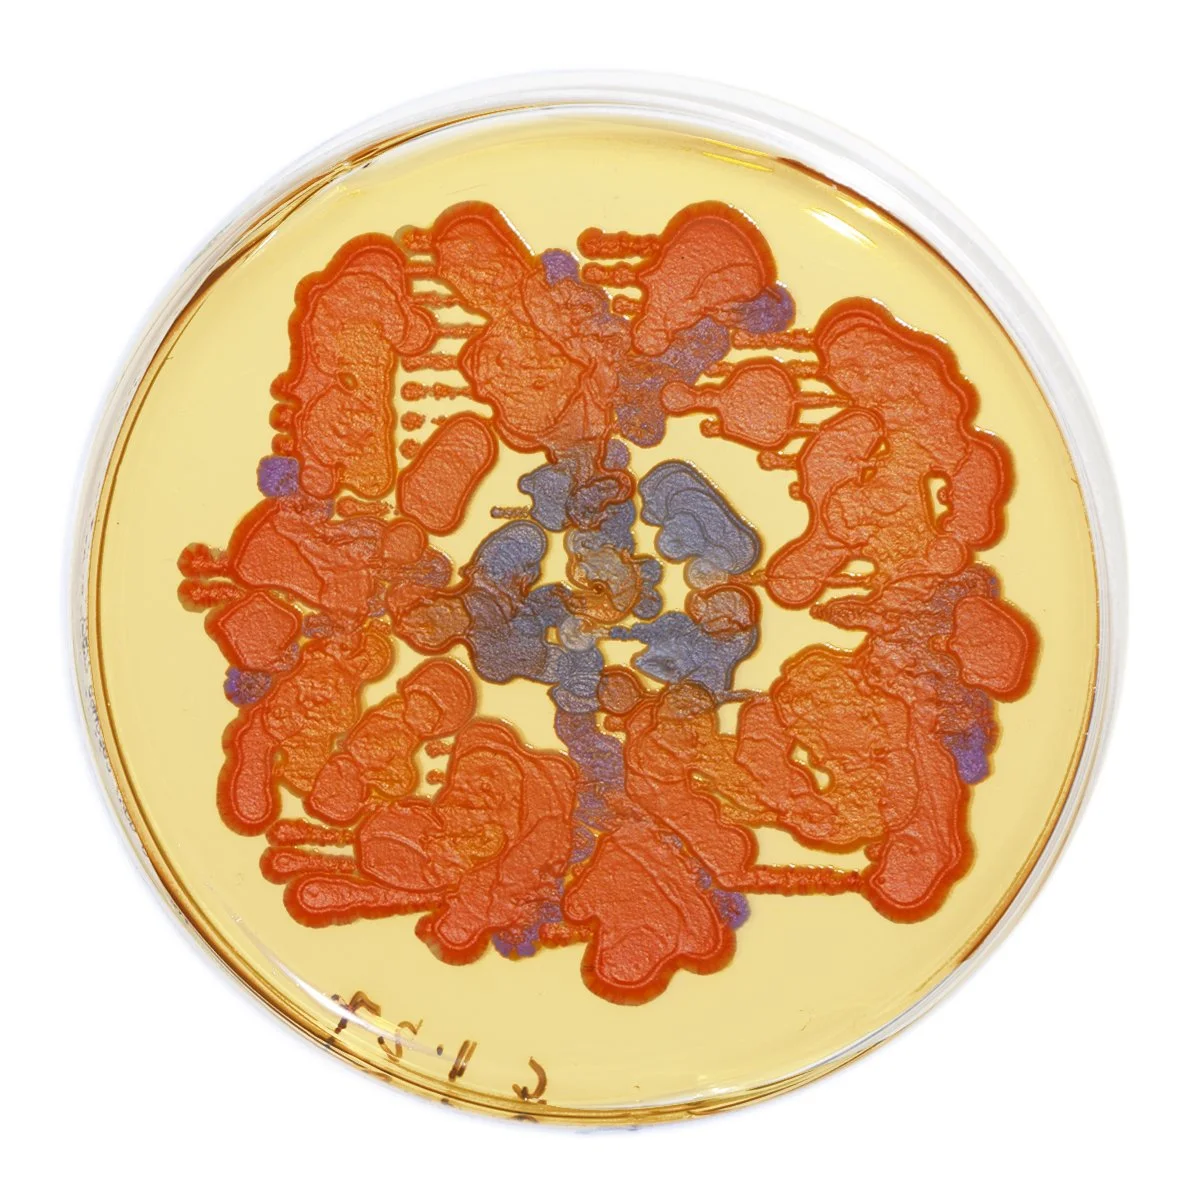

Collaborations with Genetically Modified Organisms and Robots
Image credit: Katie Gee Salisbury, 2024
“Biogenetic Blooms: Collaborations with Genetically Modified Organisms and Robots”
As part of “Biogenetic Blooms” yeast painting collaborations, BioBAT Art Space hosted a Robotic Painting Performance on Sunday February 3, 2024.
I adapted liquid handling robots, the Opentrons OT-2, to paint flowers with the modified yeast on agar. The yeast bloomed into colorful, living art. The OT-2 is a liquid-handling robot, and these particular robots,“Ron” and “Bee (pictured)” had been used for COVID testing at the height of the pandemic. The purpose of the performance was to show a multi-entity collaboration between different entities: human, robot, microbe. With the robots re-configured from testers to creators, one could ponder both the role and purpose of the robots. Even though these pieces are created with robots and predetermined templates, there is variation in each flower, much like flowers in nature encoded with DNA.
OT Blue Iris #2
OT Blue Iris #3 on YPD agar with Titanium Dioxide
OT Red Poppy #1
OT Red Poppy #2
OT Yellow Orchid #2 on YPD Agar with Charcoal
OT Yellow Orchid #1
Various adjustments in the size and spacing of the droplets of the liquid cultures of the yeast yielded different results.
Robotic Painting Performance at BioBAT ArtSpace. All photos by Katie Gee Salisbury, 2024
The digital flowers that were printed by the Opentrons OT-2 robots, “Ron” and “Bee”.
Digital images were created and separated into color screens–much like a screenprinting process–and the robot would “print” each color, one color at a time. Each flower was prototyped in food coloring on watercolor paper before printing with yeast on agar.